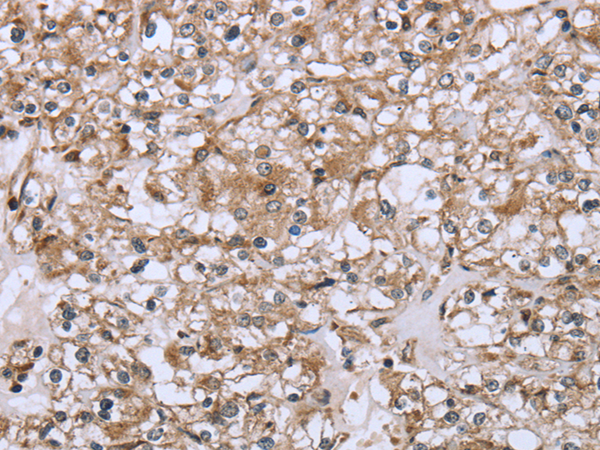
一抗

Background:
This gene is a member of the immunoglobulin gene superfamily and encodes a receptor for the Fc region of IgA. The receptor is a transmembrane glycoprotein present on the surface of myeloid lineage cells such as neutrophils, monocytes, macrophages, and eosinophils, where it mediates immunologic responses to pathogens. It interacts with IgA-opsonized targets and triggers several immunologic defense processes, including phagocytosis, antibody-dependent cell-mediated cytotoxicity, and stimulation of the release of inflammatory mediators. Multiple alternatively spliced transcript variants encoding different isoforms have been described for this gene.
Applications:
ELISA, WB, IHC
Name of antibody:
FCAR
Immunogen:
Fusion protein of human FCAR
Full name:
Immunoglobulin alpha Fc receptor
Synonyms:
CD89
SwissProt:
P24071
ELISA Recommended dilution:
2000-5000
IHC positive control:
Human liver cancer and Human prostate cancer
IHC Recommend dilution:
25-100
WB Predicted band size:
32 kDa
WB Positive control:
293T cells
WB Recommended dilution:
500-2000



 購物車
購物車 幫助
幫助
 021-54845833/15800441009
021-54845833/15800441009